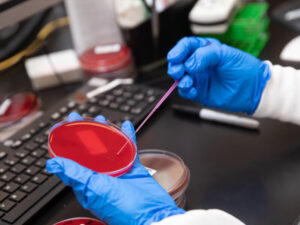
A pathologist's two gloved hands add a sample to a red petri dish in a science lab.

HOME Pathology
Podcasts
Recent Stories

New lab equips Fargo for faster diagnoses
Combining locations improves testing times for patients, collaboration for providers

On the road again: Meet the PGA TOUR COVID-19 testing crew
They've traveled thousands of miles together, becoming a family in the process

Lab workers provide answers to diagnostic questions
Sanford addresses national lab worker shortage that the pandemic intensified

Cancer survivor shares importance of 3D mammography
Pamela Harskamp wants to use her experience with breast cancer to help others

Hometown boy’s plight moves NICU nurse to donate kidney
Jan Germundson didn't know Ashton Hanson, but she felt called to help young teen

Nurse supervisor grateful for clinic’s mammogram reminder
Planning a screening day prompted Shelly Thiewes and led to cancer discovery

In grim leukemia battle, young man just kept going
Alarming complications cropped up, but nurses offered 'sense of community'

Breast cancer set nurse on a mission to help others
Two-time survivor's message: 'There is life with cancer and after cancer'

Dad shares struggles in fight against follicular lymphoma
'Dad Against Cancer' blogger Ken Santema writes to help others

PROMISE lab shows kids they can do science
Lab combines fun, facts and field trips to and from Sanford Research
Trending
Cancer
Children's Health
Heart
Orthopedics
Research
Senior Services
Innovations
- Chief physician moderates rural health innovation forum
- Sanford Health Plan president speaks at Healthapalooza
- Fortune names Sanford Health one of America’s most innovative companies
- Digital tools help free up nurses for more patient care
- Doctors teach AI to help spot cancer in image scans
- More in Innovations
News
Sanford Health Foundation
- A Week of Impact: Roger Maris All-Star Week Advances Cancer Care in Fargo
- Pours for a Purpose Raises $220,802 for Child Life in Bemidji
- Blueway Events Raise $394,210 for Cancer Care in Bismarck
- Kade’s Story: A Journey of Light, Love and Support
- Hannah’s Story: From Patient to Purpose
- More in Sanford Health Foundation
Sanford fit
- Easy Ways to Let Your Toddler Help in the Kitchen
- Mindset Matters: Building Growth Mindsets in Kids
- Tips for Raising Independent Kids
- How to Manage Your Kids' Sugar Intake Without Guilt: A Caregiver’s Guide to Healthier Habits
- The Power of Journaling: A Caregiver’s Guide to Supporting Teen Mental Health and Emotional Resilience
- More in Sanford fit